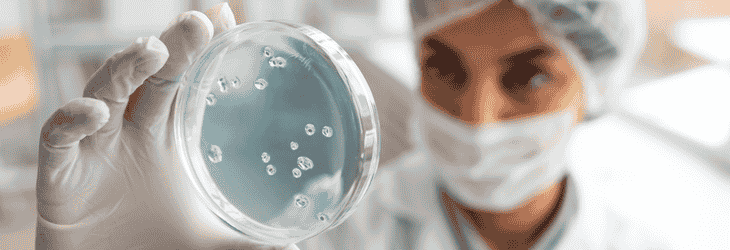

Track: Oncology Research and Innovations
Oncology research continues to revolutionize our understanding of cancer biology, paving the way for breakthroughs in cancer prevention, early detection, and cancer therapy research. This session focuses on the most recent advancements in cancer innovation, highlighting transformative discoveries that enhance diagnosis, treatment, and patient care. With contributions from leading scientists, clinicians, and researchers, discussions will span preventive oncology, cancer epidemiology, and the translation of cutting-edge laboratory findings into effective clinical practices. Attendees will gain insights into clinical studies, novel drug discoveries, and global cancer initiatives that are reshaping the future of healthcare research and improving survival outcomes.
Translational Oncology and Clinical Applications
This sub-topic explores how laboratory discoveries in oncology research are translated into clinical practice, accelerating innovative therapies, enhancing early detection programs, and improving cancer prevention strategies to ensure better patient care worldwide.
Next-Generation Cancer Therapeutics
A detailed look at innovative cancer therapy research, including immunotherapy, targeted treatments, gene-based therapies, and precision medicine approaches that aim to increase treatment success rates and minimize long-term side effects for patients.
Advancements in Cancer Diagnostics and Screening
Focus on the latest breakthroughs in molecular diagnostics, biomarker-based cancer screening, imaging techniques, and preventive oncology technologies that enable earlier cancer detection and more accurate treatment planning for high-risk populations.
Cancer Epidemiology and Public Health Innovations
Explore how cancer epidemiology guides public health interventions to reduce cancer risk factors, strengthen cancer awareness campaigns, and implement preventive oncology strategies that help lower global cancer incidence and mortality rates.
Emerging Technologies in Cancer Research
Highlight the integration of artificial intelligence, nanotechnology, and genomic sequencing in oncology research, accelerating innovative diagnostic tools, improving cancer therapy research, and enhancing early detection for diverse cancer types.
Precision Medicine in Oncology
Explore how precision medicine uses genomic data, molecular profiling, and targeted biomarkers to design personalized cancer treatments that improve therapeutic effectiveness, reduce adverse effects, and advance cancer prevention strategies.
Scientific Highlights
- Public Health & Cancer Awareness
- Cancer Prevention
- Screening & Early Detection
- Vaccination & Immunoprevention
- Environmental & Occupational Factors
- Complementary & Emerging Approaches
- Genetic & Personalized Prevention
- Cancer Biology and Genetics
- Cancer Immunology
- Molecular Oncology
- Hematology in Cancer
- Cancer Diagnosis and Therapeutic Approaches
- Oncology Research and Innovations
- Advanced Methods in Cancer Research
- Cancer Epidemiology and Prevention
- Future Trends in Prevention & Research
- Pediatric Oncology


